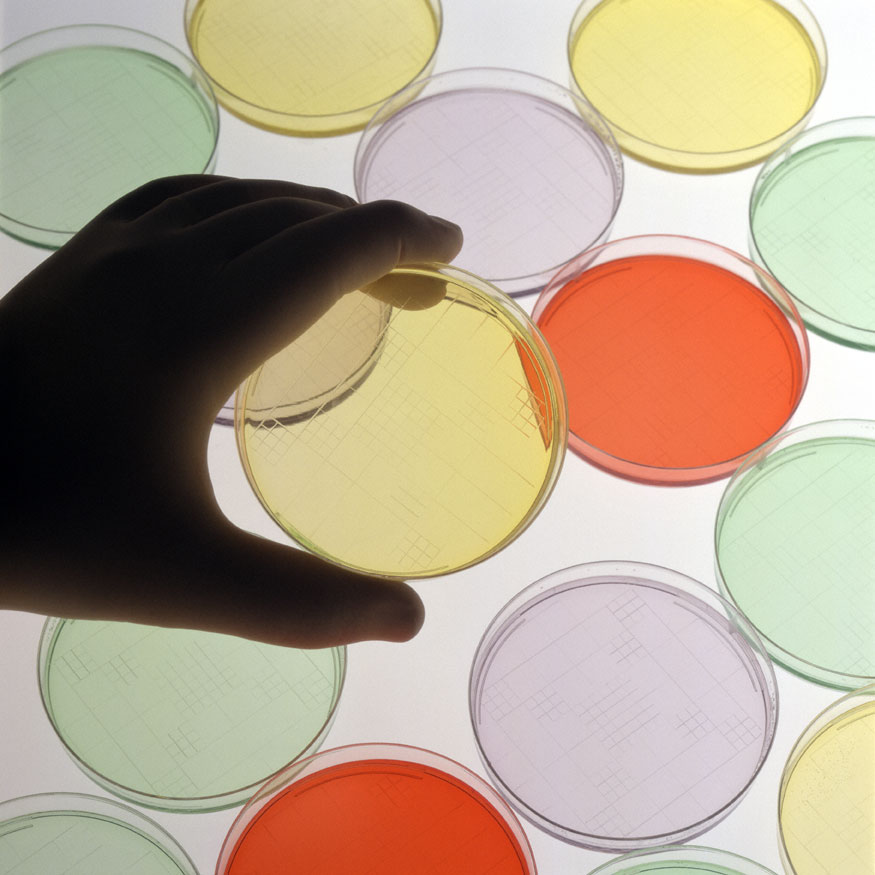
mano sujetando diferentes cultivos bacterianos

|
Miércoles, 23 de marzo de 2016
|
| Es la patología infecciosa más letal del planeta, cada 20 segundos muere una persona por tuberculosis en el mundo |
| Investigadores españoles lideran un consorcio internacional para encontrar nuevos tratamientos contra la tuberculosis |
|
mano sujetando diferentes cultivos bacterianos |
(Redacción TSB. Web del TSB)
La tuberculosis, una de las enfermedades más antiguas, que acompaña al ser humano desde la prehistoria, es ya la enfermedad infecciosa más letal del planeta y uno de los principales problemas de salud pública globales. Se estima que cada 20 segundos muere una persona en el mundo como consecuencia de esta infección. Pese a su alta prevalencia y letalidad, en los últimos 50 años no se han producido avances significativos en el desarrollo de nuevas terapias.
En la complejidad y larga duración del tratamiento actual, que combina varios fármacos con importantes efectos secundarios, está el origen de la aparición de formas resistentes de tuberculosis, contemplado como un grave problema para la salud mundial.
Por estos motivos, el lema escogido para el Día Mundial este año es Unidos para acabar con la Tuberculosis (Unite to end TB).
En los últimos cinco años y gracias a la co-financiación del 7º Programa Marco de Investigación, Desarrollo Tecnológico e Innovación de la Unión Europea, el Proyecto ORCHID, un consorcio de 13 entidades públicas y privadas, ha trabajado en descubrir y desarrollar nuevos fármacos contra la tuberculosis, con el objetivo de desarrollar un tratamiento que simplifique la administración para evitar la difusión de resistencias y cuyo coste sea viable para implementarlo en los países en desarrollo.
El proyecto, en el que participan investigadores de nuestro país, está liderado por el doctor David Barros, director del Departamento de Investigación en Tuberculosis de GSK. En las próximas semanas está previsto que se den a conocer los últimos resultados del proyecto.
Los investigadores de ORCHID han estudiado diferentes familias de fármacos: antituberculosos activos frente a célula entera, inhibidores de InhA, y beta-lactámicos, para aumentar las posibilidades de encontrar un candidato a ser nuevo tratamiento farmacológicos frente a la tuberculosis y sus formas resistentes. Como resultado de este trabajo, y también con apoyo de la UE a través del programa de cooperación de Europa y los países en desarrollo sobre ensayos clínicos EDCTP se ha realizado un ensayo clínico que replantea los beta-lactámicos, una clase de antibióticos cuyo uso contra la tuberculosis estaba previamente descartado.
En las próximas semanas está previsto que se den a conocer los resultados de este estudio, mediante su publicación en una importante revista científica.
Alrededor de medio millón de casos de tuberculosis son resistentes a las terapias actuales (75.000 de ellos, en la región europea, de acuerdo con la Organización Mundial de la Salud). Estos casos requieren un tratamiento de mayor duración (entre uno y dos años, frente a los seis meses del tratamiento estándar), más complejo y menos efectivo. Un 10% de los pacientes con tuberculosis resistente desarrollan también resistencia al tratamiento de segunda línea, lo que da lugar a una forma de tuberculosis de resistencia extrema, que causa la muerte en uno de cada dos casos.
En España, de acuerdo con los últimos datos del Instituto de Salud Carlos III, en 2014 se diagnosticaron 4.809 casos de distintos tipos de tuberculosis.
|
|
|
Eventos
|
|
Mayo 2026
|
|
L |
M |
X |
J |
V |
S |
D |
| |
| 27 |
28 |
29 |
30 |
1 |
2 |
3 |
| 4 |
5 |
6 |
7 |
8 |
9 |
10 |
| 11 |
12 |
13 |
14 |
15 |
16 |
17 |
| 18 |
19 |
20 |
21 |
22 |
23 |
24 |
| 25 |
26 |
27 |
28 |
29 |
30 |
31 |
|
|
|
|